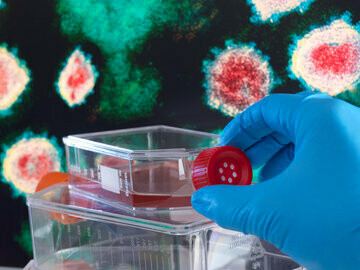
In Germany, testing for the Coronavirus is free at the point of use under both statutory and private health insurance

In Germany, 2799 patients have died of Coronavirus to date and 123,016 have been tested as carrying the virus1. The low number of deaths relative to those confirmed as infected has led to much speculation about the reasons for this state, which, to be clear, is no more than a snapshot of a rapidly evolving situation. The number of fatalities will continue to rise dramatically over the coming days and weeks. Much will depend on preventative measures to take effect, and the additional demand on treatment capacity. Yet it is also hoped that the extensive capacity available in the German health care system will be able to buffer the impact of COVID-19.
Not known for its efficiency
The stereotype associated with Germany is the efficiency of its inhabitants and industries. The same stereotype is not typically applied to describe its health care system. There are two main reasons for this: decentralization and hospital capacity. Health system governance is decentralized to the point of fragmentation, with responsibilities for organising care split between the federal government, state governments and municipalities. In addition, many governance decisions are taken by representatives of payers and providers (within the self-governing Bismarckian system), which also limits the scope for action for government. On top of that, both the funding and provision part of the system are purposefully pluralistic, with 100 statutory insurance funds in place, to name just one aspect.
In the case of the COVID-19 response, the 16 Länder (federal states) are responsible for public health decisions, leading to some states closing schools and kindergartens earlier than others (they are now all closed). While the federal minister for health, Jens Spahn, could facilitate the coordination of actions between states, he was not in the position to force them. However, by German federalist standards there has been remarkable central leadership in the fight again COVID-19. On 16 March, Chancellor Merkel, often criticised for her hesitant leadership style, took the unprecedented step to urge citizens to stay indoors and show solidarity with those vulnerable to infection2. She also explained the reasoning behind her government’s actions and the economic and social costs of shutting down public life (another omission in previous crisis management). The federal government also launched an emergency funding programme for hospitals, which includes extra payments (of Euro 50.000) for each bed made available for the intensive care and artificial ventilation3.
Large number of hospitals and hospital beds
Another efficiency concern is about hospitals and hospital beds4. Germany has a large number of hospital beds, by almost any standards. The Länder are responsible for planning and controlling hospital capacity, although many of them have used their authority to reduce capacity in the hospital sector only reluctantly. Total bed capacity stands at nearly 8 per 1000 population, compared to in 5.9 in France, 3.3 in the Netherlands and 2.5 in the UK (OECD data for 2018 or latest available).
Despite efforts to reduce hospital capacity (always hugely unpopular with citizens), there are still more than 1900 hospitals, of which about a third are in public, private and not-for- profit ownership respectively. The 35 university teaching hospitals, which run the largest intensive care units, are almost all state owned. But many hospitals are small by international standards, and some of them struggle to attract qualified professionals and to keep abreast of technological change. There have always been claims of underfunding, but funding levels have increased over time, reflecting several years of economic growth and statutory insurance surplus (counter-intuitively the Germany economy boomed in the years following the global financial crisis in 2008). Underfunding, where it exists, is nowhere near the experience of austerity shared by some of its European neighbours, although structural issues, such as those outlined above, continue to exist.
While the Länder are expected to maintain hospital infrastructure, hospitals make their own investment and purchasing decisions and have reputational and financial incentives to invest in technical equipment. This has resulted in substantial technical capacity4. There are 28,000 intensive care beds routinely available and additional beds can be made available to increase capacity for COVID-19 patients. As of 1 April, about 1850 patients are treated in intensive care5. As in other countries, most hospitals are expected to postpone elective surgery to free up hospital beds. Many patients will have to wait for their planned surgery, but it will certainly reduce pressure on stretched resources.
Testing and tracing of COVID-19 infections
There is also substantial capacity for diagnostic testing. It is estimated that 410.000 tests have been conducted to date (based on statutory insurance billing data) and capacity has been ramped up to provide up to 360.000 tests per week6. The Society for Virology currently lists 54 laboratories offering SARS-CoV-2 PCR tests, of which 28 are labs in university hospitals, 22 are in private ownership and 4 are run by public health authorities7. The Berlin based Charité, the largest teaching hospital in Europe, runs 600-700 PCR tests per day. But in addition to those large testing facilities there are a large number of privately-owned labs. The Association of Accredited Laboratories (ALM) reports that its member organisations (mostly privately owned labs and policlinics) have analysed over 260,000 samples in the week following 16 March and over 400.000 since the beginning of March8. It is difficult to develop a full picture of the German laboratory infrastructure, which is not well researched and, one suspects, less then highly regulated. Geographically, labs are unevenly distributed, with few of them located in the Eastern part of Germany; however, as long as capacity for testing is sufficient nobody seems to complain.
Testing for the Coronavirus is free at the point of use under both statutory and private health insurance. Until now, German policy-makers have tried to encourage doctors to only test those who meet certain criteria, i.e. show symptoms of COVID-19 with a demonstrable risk of infection. This was to keep the ‘worried well’ from clogging up the diagnostic supply chain. However, new guidelines published by the RKI on 25 March encourage a more lenient approach, by offering tests to everyone with symptoms, irrespective of severity, as long as there is sufficient testing capacity. The advice notes that medical personnel and vulnerable patients should be given priority if capacity reaches its limit, but the move suggests this is not a prime concern as yet. People are discouraged to pay privately for testing, although in principle, they are allowed to do so.
Doctors are required to report any positive COVID-19 testing result to the local health authority in their area. These electronically transmit these data to the RKI at least once a day, but it is acknowledged that it may take them 2-3 days to report their data in full (the statistics on the RKI website show that this sometimes takes even longer). This, in addition to staff shortages especially over the weekend, has led to delays in data reporting, which makes it difficult for the national institute to provide a precise daily account of the progression of the virus. While this may not be optimal, it is a huge improvement from the 2-3 weeks it took to alert the RKI to the outbreak of pathogenic e-coli in 2011 that claimed 53 lives9.
Despite the rising number of confirmed infections, efforts are still being made to track those who have been in contact with the infected person. To boost the capacity of overstretched local health authorities, the RKI has announced to recruit an additional 500 people as ‘scouts’ for contact tracing, principally aimed at recruiting students. The combination of testing and tracing is also seen as an important part of any future ‘exit’ strategy from the current ban on human contact in public life.
There is growing concern about the economic impact of the outbreak, with some predicting a decrease of up to 18% of GDP in the years to come10. Although measures to limit the spread of the virus are not as strict as in some other countries, people are encouraged to stay at home and to avoid any contact when they go outside. Gatherings are banned and exchanges limited to two people only unless they are members of the same household. German politicians are keen to emphasize that no curfew is exposed but a “ban on contacts”.
This week, the federal government announced a bundle of measures to protect the economy and reduce financial hardship on citizens11. This includes easy access to loans, credit assistance to companies and the provision of short-time work subsidies, which mean that companies can keep their workforce while offering shorter work hours at full pay. There are separate provisions for freelancers, artists and the self-employed. Whether this will be enough to prevent a substantial economic downturn remains to be seen. Additional emergency provisions are made in many places and differ between the Länder.
Shortage of nursing staff
Possibly the biggest challenge during the COVID-19 crisis will be the lack of nursing staff. Shortage of nursing personnel has been a long-standing concern in Germany and is partly the result of having a large number of small hospitals. Several attempts have been made to improve the pay and work conditions for nurses, and to hold hospitals to account for maintaining sufficient nursing capacity. Controversially, but not unlike other high-income countries, the German government has actively engaged in attracting nursing staff from other, often poorer, countries to fill the gaps. Some hospitals had high hopes to attract nurses returning from the UK following the Brexit referendum, but this has not happened in large enough numbers to make a material difference.
However, there is now widespread acknowledgement that this will not be sufficient to cover the need for nursing during the COVID-19 crisis, especially in critical care nursing. ICUs will need to find more qualified staff to care for the severely ill, which is perhaps the most limiting factor to expanding capacity. The government has called on retired nurses and doctors to return into service and there are regional initiatives to recruit medical students and other types of volunteers. Whether this will be sufficient to cope with the demand from COVID-19 remains to be seen.
Article by Stefanie Ettelt Associate Professor of Health Policy at the London School of Hygiene and Tropical Medicine and Klaus-Dirk Henke, Professor Emeritus of Economics (Public Finance and Health Economics), Technical University of Berlin, Department of Economics and Management, member of the Advisory Board to the German Ministry of Finance.
Notes
1 Robert Koch Institut. COVID-19 Dashboard, accessed 13 April 2020.
2 Die Bundeskanzlerin. Pressekonferenz von Bundeskanzlerin Merkel zu Maßnahmen der Bundesregierung im Zusammenhang mit dem Coronavirus, 16 March 2020, accessed 2 April 2020.
3 Bundesministerium fuer Gesundheit. Bundesrat stimmt Gesetzespaketen zur Unterstützung des Gesundheitswesens bei der Bewältigung der Corona-Epidemie zu. Press release, 28 March 2020, accessed 2 April 2020.
4 Wissenschaftlicher Beirat. Über- und Fehlversorgung in deutschen Krankenhäusern: Gründe und Reformoptionen. Berlin: Bundesministerium der Finanzen, 2018.
5 Biermann K, Blickle P, Loos A, Stahnke J, Tröger J, Venohr S. Wie viele Intensivbe!en gibt es in meiner Region? ZEIT online, 1 April 2020, accessed 2 April 2020.
6 Der Spiegel. Virologe liefert erste Erklärungen zu niedrigen Todeszahlen in Deutschland. Der Spiegel, 26 March 2020.
7 Gesellschaft fuer Virologie e.V. Diese Institute bieten SARS-Cov-2 PCR Test an, accessed 28 March 2020.
8 Akkreditierte Labore in der Medizin e.V. ALM setzt sich für einen ressourcenorientierten Einsatz der Coronavirus-SARS-CoV-2-Tests ein – fachärztliche Labore haben seit Anfang März über 400.000 Tests durchgeführt. Press release published 24 March 2020.
9 Schulte von Drach MC. Gefährlich lange Leitung im Kampf gegen die Keime. Sueddeutsche Zeitung, 17 June 2011.
10 Lauer K, Wagner R, Becker R. Ifo-Index bricht ein - "Deutsche Wirtschaft stürzt in Rezession". Reuters, 19 March 2020, accessed 28 March 2020.
11 Die Bundesregierung. Mit aller Kraft gegen die Krise.